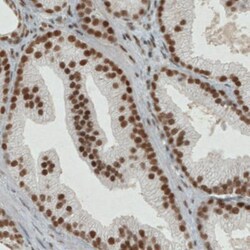
ERCC1 Antibody (CL1249), Novus Biologicals 0.1mL; Unlabeled:Antibodies,

missing translation for 'onlineSavingsMsg'
Learn More
Learn More
ERCC1 Antibody (CL1249), Novus Biologicals™
Mouse Monoclonal Antibody
Brand: Novus Biologicals NBP2-34479
This item is not returnable.
View return policy
Description
ERCC1 Monoclonal specifically detects ERCC1 in Human samples. It is validated for Immunohistochemistry, Immunocytochemistry/Immunofluorescence, Immunohistochemistry-Paraffin.
Specifications
| ERCC1 | |
| Monoclonal | |
| Unconjugated | |
| P07992 | |
| ERCC1 | |
| This antibody was developed against a recombinant protein corresponding to amino acids: LADCTLILAWSPEEAGRYLETYKAYEQKPADLLMEKLEQDFVSRVTECLTTVKSVNKTDSQTLLTTFGSLEQLIAASREDLALCPGLGPQKARRLFDVLHEPFLKVP | |
| 0.1 mL | |
| Cancer, DNA Repair, Nucleotide Excision Repair | |
| 2067 | |
| Human | |
| Purified |
| Immunohistochemistry, Immunocytochemistry, Immunofluorescence, Immunohistochemistry (Paraffin) | |
| CL1249 | |
| Immunohistochemistry 1:200 - 1:500, Immunocytochemistry/Immunofluorescence 2-10 μg/mL, Immunohistochemistry-Paraffin 1:200 - 1:500 | |
| COFS4, DNA excision repair protein ERCC-1, excision repair cross-complementing rodent repair deficiency, complementationgroup 1 (includes overlapping antisense sequence), RAD10, UV20 | |
| Mouse | |
| Protein A purified | |
| RUO | |
| Primary | |
| Specificity of antibody verified on a Protein Array containing target protein plus 383 other non-specific proteins. | |
| Store at 4C short term. Aliquot and store at -20C long term. Avoid freeze-thaw cycles. | |
| IgG2a |
Corrección del contenido de un producto
Proporcione sus comentarios sobre el contenido del producto rellenando el siguiente formulario.
Título del producto
For Research Use Only
¿Detecta una oportunidad de mejora?Comparta una corrección de contenido